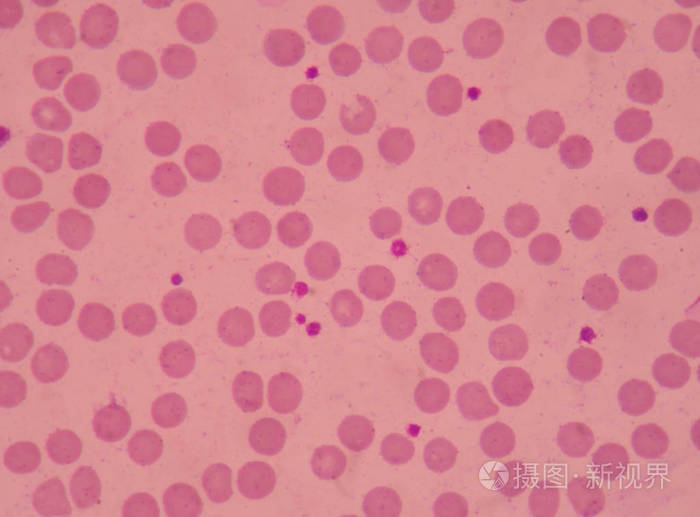
大血小板对血涂片红细胞背景的影响
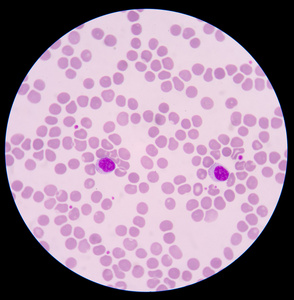
血小板减少症图片-血小板减少症素材-血小板减少症插画-摄图新视界

血涂片血小板图片
医院病人血涂片中足够的血小板计数
图片尺寸1200x890
大血小板对血涂片红细胞背景的影响
图片尺寸700x517
血小板减少症图片-血小板减少症素材-血小板减少症插画-摄图新视界
图片尺寸294x300
中医辨证:阴虚血瘀证患者邢某,女,26岁,两年前确诊为血小板增多症.
图片尺寸415x312
血小板有明显聚集却总是原因不明_医学界-助力医生临床决策和职业成长
图片尺寸403x405
血涂片显示血小板增多
图片尺寸700x673
立马拿到显微镜下仔细观察,镜下可见大血小板,与仪器提示以及血小板
图片尺寸1080x719
后来,在女性患者外周血涂片中发现有巨大血小板和中性粒细胞包涵体
图片尺寸472x345
外周血片
图片尺寸2000x2000
外周血片
图片尺寸2000x2000
外周血片
图片尺寸2000x2000血液涂片显示血小板增加.每100倍显微镜下血小板超过25个细胞.
图片尺寸1178x1100
立马拿到显微镜下仔细观察,镜下可见大血小板,与仪器提示以及血小板
图片尺寸1080x719
血小板首次 100×109/l或>1000×109/l,复检要求:涂片镜检
图片尺寸660x543
技术原理 图3 外周血涂片1000× 除了看到血小板确实是增多
图片尺寸542x534
血液肿瘤血小板聚集巨大血小板在血液涂片照片
图片尺寸296x300
学涂片请教下面血涂片有原始细胞吗
图片尺寸3264x1840
其由于是扎手指吸的血,所以血小板已经聚集成堆了,跑在了片尾,如果
图片尺寸1280x960
请在方框出显微生物 69 请教血液在显微镜下的形态 血小板:无核盘状
图片尺寸725x819
学涂片请教下面血涂片有原始细胞吗
图片尺寸3264x1840
猜你喜欢:血小板图片和血的图片血小板血涂片血小板图片止血血涂片图片血小板图片卡通图片人血永久涂片图片血小板图片大全血小板图片形态人血涂片的细胞图片血小板图片结构血小板图片手绘图血涂片单核细胞图片血小板图片白细胞血涂片细胞形态图片疟原虫图片血涂片血涂片结构图血小板图片生成血涂片各种细胞的图片正常血涂片报告单图片血涂片显微镜下图片人血涂片显微镜图片人血涂片示意图血小板高图片大全血小板白血球血涂片人血涂片鸡血涂片显微镜图片血涂片标本画图血涂片的手绘图血小板正常游戏主题蛋糕日本折纸弹跳企鹅自制东航地勤巴西兰图片拍手图片欢乐喜剧人美女演员蓝青色蓝色摩根摩托车价格锤子3pro王善朴停止接单通知图五华县水寨中学校长